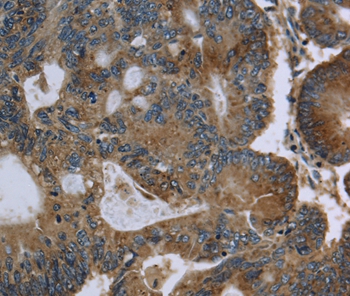
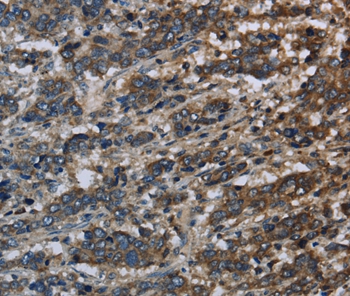
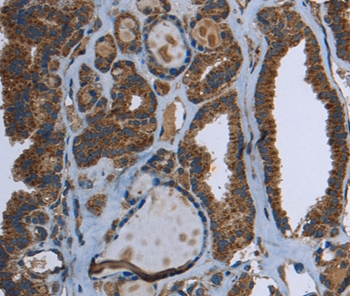
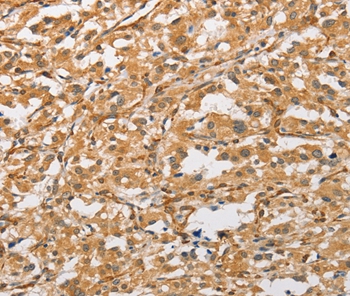

-
分类: 科研抗体货号: P42808别名: SK 2; SK-2; SPK 2; SPK-2应用: WB,IHC反应种属: Human,Mouse
-
分类: 科研抗体货号: P42807别名: SHIK; SgK495应用: WB,IHC反应种属: Human
-
分类: 科研抗体货号: P42825别名: KMT7; SET7; SET9; SET7/9应用: WB,IHC反应种属: Human
-
分类: 科研抗体货号: P42805别名: RS; RGS; ARP1; Brx1; IDG2; IGDS; IHG2; PTX2; RIEG; IGDS2; IRID2; Otlx2; RIEG1应用: WB反应种属: Human
-
分类: 科研抗体货号: P42824别名: GK1; GKD应用: IHC反应种属: Human
-
分类: 科研抗体货号: P42804别名: ORM1-like 3;ORM1-like protein 3; ORML3应用: IHC反应种属: Human
-
分类: 科研抗体货号: P42823别名: GK; GLK; HK4; HHF3; HKIV; HXKP; LGLK; MODY2; FGQTL3应用: WB,IHC反应种属: Human
-
分类: 科研抗体货号: P42803别名: ALEX1应用: IHC反应种属: Human
-
分类: 科研抗体货号: P42821别名: CF5; WID; RINF; HSPC195应用: IHC反应种属: Human,Mouse
-
分类: 科研抗体货号: P42801别名: ANX31应用: WB,IHC反应种属: Human

鄂公网安备42018502007531号
鄂公网安备42018502007531号

